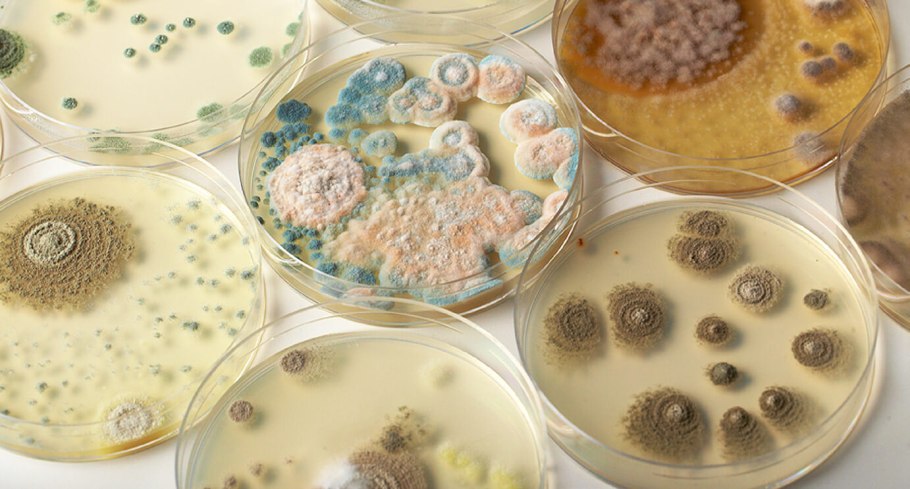
Микотоксикозы микроскопические грибы
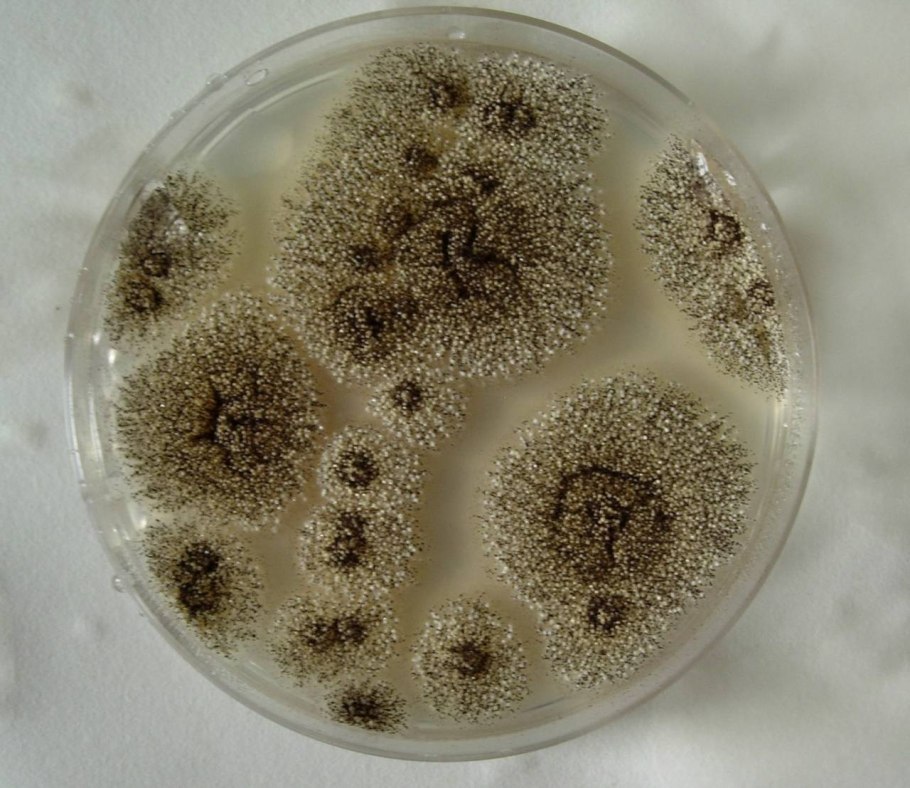
Аспергилл гриб
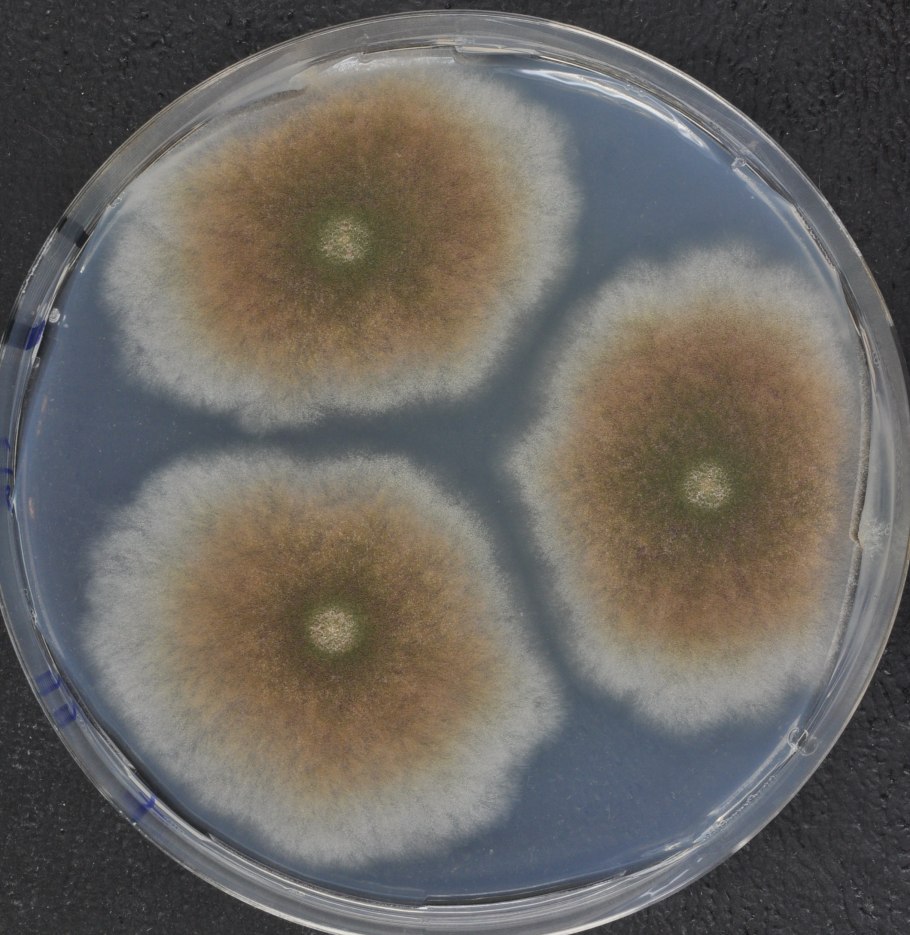
Бактерия аспергиллус
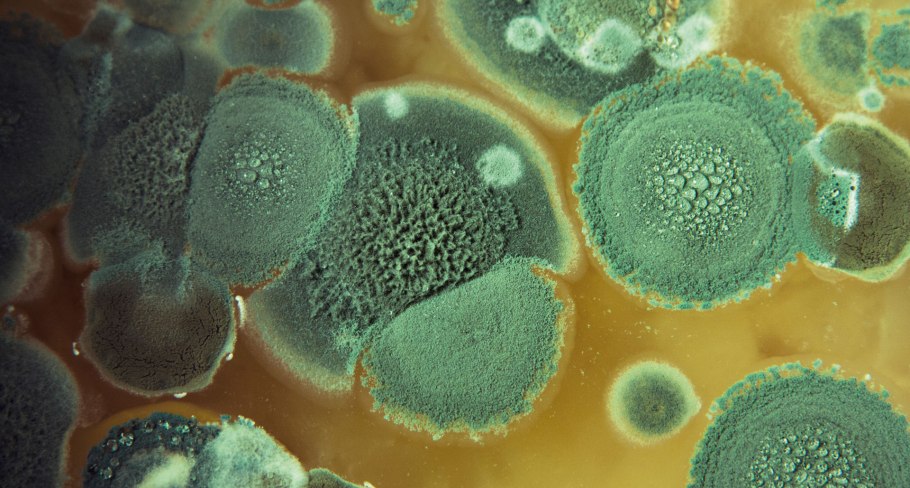
Дерматомикоз эпидермофития

Патогенные грибы (45 фото)

Плесневые грибы аспергиллус

Аспергиллус охрацеус

Пенициллиум микробиология

Аспергиллус микроскопия

Aspergillus fumigatus микроскоп

Грибок трихофитон рубрум
Микотоксикозы микроскопические грибы

Кандида альбиканс

Чашка Петри с бактериями

Плесневые грибы грибы аспергилл

Возбудитель грибка кандида

Плесневые грибы грибы аспергилл

Aspergillus nidulans

Плесень в чашке Петри

Дрожжеподобные грибы кандида
Аспергилл гриб

Патогенные грибы в почве

Aspergillus ustus

Кандида альбиканс микроскопия

Аспергилл и мукор

Грибок аспергиллус

Гриб триходерма вериде

Дрожжеподобные грибы рода кандида

Дрожжеподобными грибами рода Candida

Кандида альбиканс

Candida Auris под микроскопом

Виды бактерии стоматита

Trichophyton mentagrophytes

Грибок кандида под микроскопом

Кандида золотистая

Кандида золотистая

Грибок трихофитон рубрум

Конидиеносец Aspergillus

Аспергилла грибок

Аскомицеты патоген

Aspergillus по грамму

Candida albicans под микроскопом
Бактерия аспергиллус

Грибок Aspergillus flavus.
Дерматомикоз эпидермофития

Аспергилла Нигра это

Aspergillus микробиология

Микробиология чашки Петри Сабуро

Плесневые грибы аспергиллус

Aspergillus fumigatus микроскоп
Поделиться фото в социальных сетях:
Комментариев (0)
Похожие фото:











